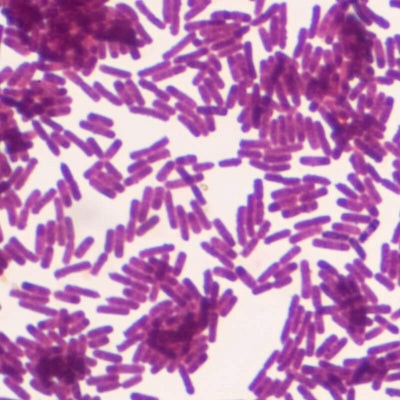
beauty products

¿TE SUENA?
Con la perimenopausia y la menopausia te puede estar pasando esto
Y no, no estás sola. Millones de mujeres experimentan estos cambios.
Notas más pelo en el cepillo
Cada mañana ves más pelo del que te gustaría. En la almohada, en la ducha, en tu ropa.
Tu pelo ha perdido densidad
Ya no tiene el volumen de antes. Las coletas son más finas y la raya se ve más ancha.
Los cambios hormonales te afectan
Sofocos, insomnio, estrés... y todo esto también impacta en tu pelo.
Tomas varios suplementos
Colágeno, biotina, vitaminas... y no sabes si realmente están funcionando.
LA SOLUCIÓN
Un solo vial que sustituye a todos tus suplementos
Olistic NEXT está diseñado por expertos para abordar las causas raíz de los cambios de la menopausia y potenciar tu bienestar general.
Ayuda a reducir la caída desde el primer mes
Favorece el crecimiento de un cabello más fuerte
Refuerza piel y uñas durante esta etapa de cambio
Resultados de clientas reales
Resultados esperados
¿Cuándo empezaré a notar resultados?
El pelo tiene su propio ciclo. Esto es lo que puedes esperar:
Mes 1-2
Menos pelo en el cepillo.
Empiezas a notar que la caída se frena.
Mes 4-5
Nuevos cabellos. Empiezas a ver "pelitos" nuevos en la línea del pelo.

INGREDIENTES
+35 ingredientes naturales que marcan la diferencia
Aswaganda, cúrcuma, saw palmetto, epilobo, zinc, biotina, vitamina D, +28 más….
Multifactorial: Ataca estrés, hormonas, piel, nutrición, inflamación y envejecimiento.
100% natural: Sin efectos secundarios. Apto para uso prolongado.
Formato bebible para una máxima absorción.
Respaldado científicamente
Esto es Olistic
Profesionales y clientas nos hablan sobre Olistic.
Así hablan de nosotros
FAQ
Preguntas frecuentes
Estamos aquí para ayudarte.
¿Cuándo empezaré a notar resultados?
La mayoría de mujeres notan menos caída a partir de los 3 meses. Los resultados visibles en densidad suelen verse a los 6 meses con uso continuado.
¿Es seguro? ¿Tiene efectos secundarios?
¿Puedo cancelar la suscripción cuando quiera?
¿Hay efecto rebote si lo dejo?
¿Olistic Women o Olistic NEXT ¿Cuál es para mí?
*IQVIA: nº1 en Farmacias TAM junio' 25 en valores en el mercado de anticaída 86H2 en España.











